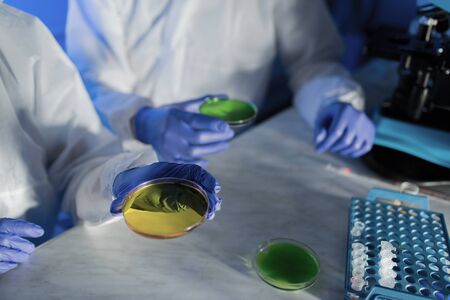
science, chemistry and people concept - close up of scientists with chemical samples in petri dish making test or research at laboratoryの写真素材

写真素材 - science, chemistry and people concept - close up of scientists with chemical samples in petri dish making test or research at laboratory
作品情報
science, chemistry and people concept - close up of scientists with chemical samples in petri dish making test or research at laboratory
- ID:52257163
- 作品種別:写真
- 作者名:dolgachov
キーワード
- backroom
- biochemistry
- biological
- biotechnology
- chemical
- chemistry
- chemists
- clinical
- closeup
- closup
- concept
- discovering
- discovery
- dish
- experiment
- expertise
- fluid
- hands
- holding
- indoors
- lab
- laboratory
- liquid
- man
- medical
- medicine
- nuclear
- people
- person
- perti
- professionals
- protective
- research
- researchers
- researching
- samples
- science
- scientific
- scientists
- specialists
- technicians
- terrorism
- test
- toxic
- weapon
- woman
- workwear
類似作品
Scientist man a...
the doctor hold...
Science student...
A young woman d...
Scientist pipet...
Experiments in ...
A girl laborato...
group of labora...
A young woman d...
Excited science...
Abstract virtua...
Scientist man w...
Medical study o...
laboratory glas...
Creative chemis...
group of labora...
Student holding...
Doctor in prote...
Researchers wor...
Young scientist...
Science student...
Creative chemis...
A man with a be...
Two young men s...
Young woman mix...
Abstract virtua...
in the backgrou...
Researchers wor...
Scientist man a...
Hand of unrecog...
Researchers wor...
The girl is hol...
Scientists in c...
Portrait of a w...
Collaboration, ...
Abstract virtua...
Team of researc...
Science student...
group of young ...
Confident teach...
Medical science...
group of labora...
close up.a grou...
Scientist worki...
Science student...
Chemical reacti...
COVID-19 Testin...
Two young woman...
Creative chemis...